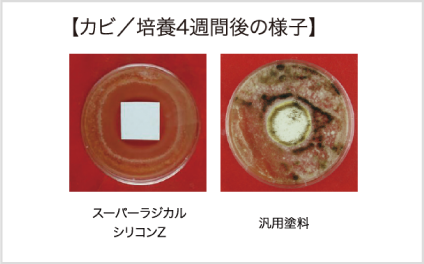

外壁
スーパーラジカル
シリコンZ
塗膜の劣化要因“ラジカル”を抑え
長期間にわたり建物を保護します。
長期間にわたり建物を保護します。
-
期待耐用年数10~12年
-
低汚染性〇
-
遮熱性-
-
防水性-
-
防カビ・防藻性〇
-
色69色

製品スペック
機能
色・事例
製品仕様
特長
耐候性
ラジカルによる塗膜の劣化を抑え、長期間にわたり建物を保護
促進耐候性試験(キセノンランプ式)において、約10~12年(期待耐用年数)経過後も光沢保持率80%以上を保持。塗膜の劣化要因であるラジカルの発生を抑制し、建物を長期間保護します。
※あくまで試験環境下にもとづく推測値であり、耐候性を保証するものではありません。実際の自然ばく露環境下では、下地の状態、施工方法、気象条件により耐候性は異なる場合があります。
※測定値を元に、グラフをなだらかに調整しています。
※あくまで試験環境下にもとづく推測値であり、耐候性を保証するものではありません。実際の自然ばく露環境下では、下地の状態、施工方法、気象条件により耐候性は異なる場合があります。
※測定値を元に、グラフをなだらかに調整しています。

<技術>ラジカル制御型白色顔料を配合
ラジカルの発生を抑制する「ラジカル制御型白色顔料」を採用。ラジカルが発生しにくく、またラジカルが発生した場合にも、シールド層がラジカルの放出を防ぐため、樹脂が破壊されにくく、塗膜の劣化を抑制します。

特長
低汚染性
汚れが付着しにくく、美観を長期間保持
柔軟層と強靭層から構成される二重構造アクリルシリコン樹脂を採用。一般的なシリコン塗料に使用されているアクリルシリコン樹脂は表層の柔軟性が高く、汚れが付着しやすい課題を抱えていますが、この二重構造樹脂は柔軟性のある層を強靭な層でコーティングしています。この構造により、塗膜表面に汚れが付着しにくく、建物の美観を保持します。

二重構造のアクリルシリコン樹脂
特長
防カビ・防藻性
カビや藻の発生を防ぎ、美観の保持に貢献
「JIS Z 2911 かび抵抗性試験方法」および「藻抵抗性試験(社内試験による)」に合格。カビ・藻の発生を抑え、美観の維持に貢献します。
カビ/培養4週間後の様子

藻/培養4週間後の様子
よくある質問
『期待耐用年数』とは?
『塗布量』とは?
『塗装ロス』とは?
『希釈(量)』とは?
『工程内間隔』とは?
『工程間間隔』とは?









































































